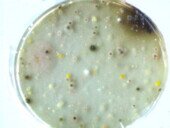

38UWGewässer
SEKUNDARSTUFEN
38UMGewässer
Gewässer
Experimente und Informationen:
Einfluss von Salzen, pHWert Nachweise für Salze, Leitfähigkeitmessungen Umkippen eines Gewässers Nachweise für Wasserbakterien Giftstoffe Giftwirkung (Kressetest), Geruch mit Farbtest und Test auf Sinkstoffe Güteklasse Sauerstoffnachweis Sauerstoffzehrung
biologischer Nachweis der Wassergüte Güteklassen1234
vgl auch Biotechnik Bakterienvgl auch Grundschule Wasser
Gewässer Große Mengen von Wasser kommen als Süßwasser in Flüssen und Seen vor, ebenso im Grundwasser. Sehr viel Wasser ist auch im Eis der Arktis und Antarktis gespeichert. Meerwasser ist für den Menschen nicht genießbar.Auf Grund des Wasserbedarfs der Menschen und der Landwirtschaft ist an vielen Orten das Wasser knapp geworden. Ohne Wasser gibt es keine Lebensgrundlage für den Menschen. Die Sauberhaltung von Gewässern aller Art. Seen, Bäche, Flüsse und Meere haben eine große Bedeutung. Das Grundwasser und viele Flüsse dienen als Reservoir für das Trinkwasser, Gewässer stellten und stellen vielerorts die Grundlage für Fische und Fischerei. Die Gewässer dienen aber auch als Abfallgruben für Plastik, Chemikalien und Abwässer aller Art. Eine Reihe von Versuchen soll einen experimentellen Einblick in Gewässer geben. Leitfähigkeitsmessungen: Da die meisten Salze mehr oder weniger in Wasser dissoziieren, kann man mit der Leitfähigkeitsmessung einen ersten Hinweis auf die Salzbelastung erhalten, ohne eine chemische Analyse durchführen zu müssen. (Vgl http://www.laborpraxis.vogel.de/analytik/titration/elektroden/articles/260783/)
Für die weiteren hier genannten Bestimmungen gibt es käufliche Testbestecke. Kalziumcarbonate (= Wasserhärte) Als Wasserhärte beschreibt man anschaulich das Verhalten des Wassers beim Waschvorgang: je "härter" das Wasser, umso mehr Seife benötigt man, um den gleichen Wascheffekt zu erzielen. Die Wasserhärte wird durch den Gehalt an Kalzium- und Magnesiumsalzen bewirkt. Das Kalziumcarbonat verursacht die sog. Karbonathärte, die durch Aufkochen des Wassers entfernt werden kann. In der Hitze fällt unlösliches Kalziumcarbonat als „Kesselstein“ aus. Die restliche Härte geht auf Kalziumsulfat oder Kalziumchlorid zurück, die wasserlöslich bleiben, aber eine sehr geringere Rolle spielen. Sulfate Sie sind kaum gesundheitsschädlich, wirken aber ab 250 ppm im Trinkwasser abführend. Diesen Effekt macht man sich bei "Wasserkuren" zunutze. Für das Bauwesen und die Technik ist der Sulfatgehalt von größter Bedeutung: Mörtel, Beton und Zement werden schon bei Konzentrationen ab 150 ppm angegriffen. Dabei wird der feste Mörtel - bestehend aus Kalciumcarbonat - in das amorphe und bröckelige Kalziumsulfat umgewandelt: Ein aus Sandstein gebautes Bauwerk bricht auf lange Sicht bei „saurem“ Regen, der SO2 enthält, zusammen. Im biologischen Bereich deuten hohe Sulfatkonzentrationen auf eine Belastung mit Fäkalien hin, da der in den Eiweißen enthaltene Schwefel im Wasser in Sulfat oxydiert wird. Chlorid Kochsalz Ein Erwachsener scheidet täglich im Harn etwa 10 bis 15g Kochsalz aus. Findet man einen Gehalt von mehr als 30 ppm im Flusswasser, so deutet dies auf eine Einleitung von Fäkalien hin. Der Gehalt an Kochsalz kann durch Kläranlagen nicht verändert werden. Hohe Kochsalzkonzentrationen weisen also darauf hin, ob das Wasser schon durch eine Kläranlage gelaufen ist, auch wenn Nitrate und organische Bestandteile fehlen. Phosphate stellen die wesentliche Ursache für das Umkippen von Gewässern dar. In normalen Ökosystemen stellen Phosphatsalze Minimumfaktoren dar, die das Wachstum der Organismen einschränken. Gelangen durch menschliche Fäkalien oder Überdüngung vermehrt Phosphate in Gewässer, so steigt die Bioproduktion daher rapide an, mit dem Nachteil eines Sauerstoffdefizits im Wassern („Algenblüte“ bis Umkippen eines Gewässers). Ca. 50 % der Phosphate stammen aus Waschmitteln, aus Überdüngung 30%. In Kläranlagen müssen die Phosphatsalze umständlich und teuer mit Eisensalzen ausgefällt werden. Die einfachste Methode für gutes Wasser ist die Vermeidung. Nitratsalze Nitrate sind die Salze der Salpetersäure. Sie sind in fast jedem Wasser in Mengen zwischen 5 und 10 ppm enthalten. Nitrate sind im Allgemeinen nicht gesundheitsschädlich, ein hoher Nitratgehalt deutet jedoch auf Belastung mit organischen Abwässern hin, hohe Nitratgehalte sind also hygienisch bedenklich. Nitrite sind wesentlich gefährlicher. Es sind dies die Salze der salpetrigen Säure. Sie können durch bakterielle Reduktion von Nitraten entstehen. Außerdem benutzt man Nitrit, um eine Rotfärbung der Wurst und des Fleisches zu erlangen. Durch Nitrite oder durch die Reduktion von Nitrat im Darm durch die Bakterienflora zu Nitriten können schwere Atmungsvergiftungen entstehen, da Nitrit das Hämoglobin der roten Blutkörperchen angreift (Blausucht bei Kleinkindern). Heute gelangt das allermeiste Nitrat durch Überdüngung in Trinkwasser bzw. in Gemüse und andere Nahrungsmittel. Der Nitratgehalt im Trinkwasser der BRD darf seit 1985 nicht über 25 ppm liegen! (EG-Richtwert). Bis 2023 hält die BRD diese Werte nicht ein. Ammoniak (NH3) ist ein stechend riechendes Gas (Gülle!), dass die Schleimhäute angreift und ein gefährliches Zellgift darstellt. Mit Wasser reagiert das Gas heftig zu Ammoniumionen: NH3 + H2O -------> NH4+ + OH-. Die Prüfung auf Ammonium- Ionen ist deswegen interessant, weil das Gas Ammoniak die Endstufe des organischen Stickstoffabbaus ist. Ein Gehalt von Ammoniak in der Luft oder in der Wasserprobe lässt also auf das Vorhandensein von Eiweißverbindungen schließen, die meist auf die Einleitung von Fäkalien durch den Menschen zurückgehen (Ausnahme: Moorwasser!). Der Nachweis von Ammoniak ist der rascheste und sicherste Hinweis auf organische Verschmutzung. TRINKWASSER DARF KEIN AMMONIAK ENTHALTEN! Richtwerte für Ammoniak bzw. Nitrat: Bachwasser: unter 0,1 mg NH3 ppm; Schmutzwasser: 0,1 bis 10 mg NH3 ppm | ||
Versuch 1
Nachweise von Salzen mit Teststäbchen
Für die hier genannten Bestimmungen gibt es käufliche Testbestecke.
Teste nach den Vorschriften ein Bachwasser deiner Wahl und zum Vergleich Leitungswasser!
Wasserhärte: (= Carbonat Salze) Test nach Vorschrift (Testpack)
Bachwasser: ……………. Leitungswasser …………….
Übersicht über die Härtegrade des Trinkwassers

Sulfatsalze:
Nachweis mit modernen Teststäbchen nach Arbeitsvorschrift: vgl. Arbeitsvorschrift.
Nachweisreaktion: Thorin- Ba + H2SO4 ---> BaSO4 (weiss) + Thorin (gelb)
Bachwasser: ……………. Leitungswasser …………….
Clorsalze:
Chloridionen gehen mit Quecksilber eine praktisch unlösliche Verbindung ein. überschüssige Chloridionen bilden dann mit einem zugesetzten Farbstoff einen blauvioletten Komplex (vgl. Packungsbeilage).
Bachwasser: ……………. Leitungswasser …………….
Phosphatsalze:
Phosphate bilden mit Molybdänsäure einen gelben Komplex, der durch Reduktion in einen blauen Komplex umgebaut werden kann. Die Blaufärbung ist ein Maß für die Menge des ursprünglich vorhandenen Phosphats (vgl. Testpack).
Bachwasser: ……………. Leitungswasser …………….
Nitrat
Auf dem Teststäbchen wird auch Nitrit angezeigt. Das Nitrat wird zu Nitrit reduziert, die salpetrige Säure verbindet sich mit einem Farbstoff zu einem rot- violetten Farbstoffkomplex (Azo- verbindung).
Ammoniumsalze
Sie bilden mit Nesslers Reagenz eine typische Gelbfärbung. Der Test muss immer in saurem Milieu (pH-Wert unter 6.0) vorgenommen werden, da nur dann sich im Wasser das Ammoniumion bildet. Das Testreagenz ist sehr g i f t i g!! Meist kann man auf den Test verzichten, denn Ammoniak ist leicht zu riechen (Geruch nach Gülle)
Bachwasser: ……………. Leitungswasser …………….
Versuch 2
pH- Wert von wässrigen Lösungen
Zur Charakterisierung von Wasserproben hat sich der pH-Wert sehr gut bewährt. Er ist auch ökologisch von größter Bedeutung für die Überlebensfähigkeit der Lebewesen, da die meisten Lebewesen nur in einem kleinen „Fenster“ des pH-Werts überleben können. (Inzwischen kennt man aber einige Bakterien, die auch in extremen pH-Werten (um pH1) leben und dort ihre maximale Vermehrungsrate haben)
pH-Wert-Skala:
pH-Wert-Skala:
sauer... neutral
....... ......basisch.....
1
2
3 4
5
6 7
8 9
10 11
12 13 14
Leben möglich
zwischen rund 5.5 und 7.8
Grundlagen: In sehr reinem Wasser findet man infolge der Selbstdissoziation etwa 10 -7 Mole Protonen (richtiger: Oxoniumionen) und entsprechend auch 10 -7 Mole Hydroxoniumionen in 1000 ml Wasser. Gibt man eine Säure zu, so entstehen mehr Protonen und entsprechend weniger Hydroxoiumionen. Bei einer sog. "Lauge" ist das umgekehrt. Um nicht mit so sehr kleinen Zahlen rechnen zu müssen, hat man den pH-Wert eingeführt und definiert:
Der Begriff pH leitet sich von pondus Hydrogenii oder potentia Hydrogenii
sauer: Autobatterie: 0-1; Magensäure: 1-2;
sauer: Autobatterie: 0-1; Magensäure: 1-2;
Saurer Regen 4 bis 5;
Bleichmittel 12.5; Beton 12,5; Natronlauge um 13
pH = -10log Konz (H3O+)
(lat. pondus = Gewicht; lat. potentia = Kraft; lat. hydrogenium = Wasserstoff) ab.
(http://de.wikipedia.org/wiki/PH-Wert
einige pH-Werte:
Zitronensaft 2,5; Essig 2,5; Wein 4,0;
Fast neutral: Meerwasser 7,5; Blut 7,4; Milch 6-8
Alkalisch: Darmsaft 8,3; Seife 9-10; Waschmittel: 8;
Messung von pH-Werten
Am einfachsten misst man den pH-Wert mit sogenanntem Indikatorpapier.
Das ist ein Papier, das mit einem Farbstoff getränkt ist, der bei einem bestimmten pH-Wert seine Farbe ändert.
Aufgabe1: Vergleiche verschiedene pH-Wert Papiere und stelle fest, ob man denselben pH-Wert ablesen kann.
Man kann den pH-Wert mit einem elektrischen Gerät sehr genau messen.
Aufgabe 2: Stelle den pH-Wert in verschiedenen wässrigen Lösungen fest:
Protokoll:
Aufgabe 2: Stelle den pH-Wert in verschiedenen wässrigen Lösungen fest:
Protokoll:

Versuch 3
Nachweis von Chlorid
Kochsalz kommt praktisch in jedem Wasser vor, zwischen 10 und 100 ppm im Meerwasser. Ein Erwachsener scheidet täglich im Harn etwa 10 bis 15 g Kochsalz aus. Findet man einen Gehalt von mehr als 30 ppm im Flusswasser, so deutet dies auf eine Einleitung von Fäkalien hin.
Durch Kläranlagen wird der Kochsalzgehalt nicht verändert.
Test:
Beschreibung auf der Packung mit den Teststäbchen:
Chloridionen gehen mit Quecksilber eine praktisch unlösliche Verbindung ein. überschüssige Chloridionen bilden dann mit einem Farbstoff einen blauvioletten Komplex.
Aufgabe: Bestimme in verschiedenen Wasserproben den Chloridgehalt!

Versuch 4
Nachweis von Sulfat
Sulfate, die Salze der Schwefelsäure, kommen normalerweise nur in sehr geringen Mengen im Wasser vor. Werden Gipslagerstätten vom Wasserfluss berührt, steigen allerdings die Sulfatgehalte auf 1000 ppm an.
ppm = pars per Million
ist die eingeführte Konzentrationsbezeichnung im Umweltschutz
Sulfate sind kaum gesundheitsschädlich, sie wirken aber ab 250 ppm im Trinkwasser abführend. Diesen Effekt macht man sich bei medizinischen "Wasserkuren" zunutze.
Für die Technik ist der Sulfatgehalt allerdings von größter Bedeutung: Mörtel, Beton und Zement werden schon bei Konzentrationen ab 150 ppm angegriffen. Dabei wird der feste Mörtel - bestehend aus Calciumcarbonat - in das amorphe und bröckelige Kalziumsulfat umgewandelt: Das Bauwerk bricht auf lange Sicht zusammen (siehe Innenstadt Freiburg: Münsterdiskussion). Mit Spezialbeton wird versucht, die Schäden zu verhindern.
Im biologischen Bereich deuten hohe Sulfatkonzentrationen auf eine Belastung mit Fäkalien hin, da der in den Eiweißen enthaltene Schwefel im Wasser in Sulfat aufoxydiert wird.
Test:
Mit modernen Teststäbchen, vgl. Arbeitsvorschrift.
Die Zonen auf dem Teststäbchen enthalten einen roten Thorin- Barium- Komplex, der sich bei Berührung mit Sulfat aufspaltet und das gelbe Thorin freisetzt. Es entsteht dabei gleichzeitig das weiße Bariumsulfat.
Thorin- Ba + H2SO4 -------- BaSO4 + Thorin (gelb)
Versuch: Testen Sie Wasser aus einem Bach, aus einem Abwasserteich, aus dem Regenwasser und aus der Leitung!
Ergebnisse:
Versuch 5
Nachweis von Phosphat
Aufgabe: Stellen Sie den Text als Grafik dar und betonen Sie die gegenseitigen Wirkungen.
Test:
Phosphate bilden mit Molybdänsäure einen gelben Komplex, der durch Reduktion in einen blauen Komplex umgebaut werden kann. Die Blaufärbung ist ein Maß für die Menge des ursprünglich vorhandenen Phosphats (vgl. Testpack).
Phosphate bilden mit Molybdänsäure einen gelben Komplex, der durch Reduktion in einen blauen Komplex umgebaut werden kann. Die Blaufärbung ist ein Maß für die Menge des ursprünglich vorhandenen Phosphats (vgl. Testpack).
Aufgabe: Bestimme den Phosphatgehalt in verschiedenen, sinnvoll ausgewählten Wasserproben:

"Umkippen" eines Gewässers Die Zunahme der Bioproduktion im Sommer hat vor allem im Herbst, wenn der größte Teil der Biomasse abstirbt, eine verstärkte Sauerstoffzehrung zur Folge, da die abbauenden - veratmenden Lebewesen, die Destruenten - Sauerstoff benötigen. Dies führt auf dem Grunde der Seen zu einem akuten Sauerstoffmangel, da durch Diffusion alleine Sauerstoff aus der Luft zu wenig rasch nachgeliefert wird. Umkippen: Die Konsumenten, die Sauerstoff benötigen, sterben und die anaerob lebenden Bakterien nehmen zu. Sie produzieren Methan, Schwefelwasserstoff, Ammoniak, - alles für aerob lebende Organismen tödliche Gifte: Das Gewässer "kippt um": es bildet sich - unter Umständen irreversibel - ein neues, diesmal aber anaerobes Ökosystem, das sich selbst stabilisiert solange organisches Material nachgeliefert wird. So sind z.B. die tiefen Bereiche der Ostsee schon anaerob, d.h. "umgekippt". dies beruht auf eingekippten Abfällen, die verrotten und auf einer zu geringen Sauerstoffzufuhr. | |||
Versuch 6
Kalkgehalt von Gewässern: Wasser Härte
Kalziumcarbonate (= Wasserhärte)
Als Wasserhärte beschreibt man anschaulich das Verhalten des Wassers beim Waschvorgang: je "härter" das Wasser, umso mehr Seife benötigt man, um den gleichen Wascheffekt zu erzielen.
Die Wasserhärte wird durch den Gehalt an Calzium- und Magnesiumsalzen bewirkt. Das Calziumcarbonat verursacht die sog. Carbonat härte, die durch Aufkochen des Wassers entfernt werden kann. In der Hitze fällt unlösliches Calziumcarbonat als „Kesselstein“ aus. Die restliche Härte geht auf Kalziumsulfat oder Kalziumchlorid zurück, die wasserlöslich bleiben, aber eine sehr geringere Rolle bei der Wasserhärte spielen.
Überprüfung der Wasserhärte:
Test nach Vorschrift (Testpack)

Leitfähigkeit
Leitfähigkeit als Indikator für Verunreinigungen Prinzip: Je höher die Leitfähigkeit, umso geringer ist der Widerstand, der dem Strom entgegengesetzt wird. Man misst daher die Leitfähigkeit als Umkehrung des Widerstands: Leitfähigkeit = a 1 / R (a=Stoffkonstante und Faktor der Zelle, in der man misst), R= Widerstand Um eine Abscheidung der Ionen zu vermeiden, nutzt man nur rund 20 Volt Wechselstrom. Bei verdünnten Lösungen ist die Leitfähigkeit direkt proportional der Konzentration der Ionen in der Lösung. Daher ist die Leitfähigkeitsmessung eine sehr rasche und genaue Methode zur Messung von Verunreinigungen in Wasser. Je mehr Jonen, umso höher die Strommenge. Die gefundenen mA sind daher ein direktes Maß für die Jonen Menge im Wasser. Es gilt nach dem Ohm’schen Gesetz: U= R x J oder R= U / J Oder durch Umrechnung: Leitfähigkeit = a / U x J J= Strommenge in mA, R = Widerstand, U = Spannung Die Leitfähigkeit des Wassers ist ein Maß für die Belastung des Wassers mit Ionen (Partikel, die im elektrischen Feld wandern) oder - etwas ungenau - ein Maß für die Belastung des Wassers mit Salzen aller Art. Reines Wasser leitet den Strom fast nicht, Je mehr Ionen darin enthalten sind, umso höher ist die Leitfähigkeit. Sie hängt allgemein ab von der Anzahl der elektrisch geladenen Teilchen im Wasser, dies sind meist Salze. Man kann daher von der Höhe der Leitfähigkeit auf die Salzbelastung schließen, ohne eine chemische Analyse durchführen zu müssen. | ||
Versuch 7
Messung der Leitfähigkeit des Gewässers
als Maß für den ökologischen Zustand
Messgerät zur Erfassung der
Leitfähigkeit

Ablauf der Messung:
1) Halte die Sonde in die zu prüfende Wasserprobe.2) Schalte das Gerät ein und halte den Messwert fest.3) Überprüfe die Messung, indem Du einen weiteren Test mit destilliertemund wieder abgekühltem Wasser machst. Die Leitfähigkeit muss sehr gering sein.4) Messe die Leitfähigkeiten in verschiedenen Wasserproben.
Die Leitfähigkeit gibt noch nicht an, wie viel Salz in den Wasserproben ist. Daher ist eine Eichkurve mit Kochsalz notwendig:
Erstellung einer Eichkurve:
Man stellt sich eine Konzentrationsreihe mit Kochsalz her:
- Ausgangslösung ist eine Lösung von 10g NaCl in 100ml Wasser. (1)
- Davon nimmt man 50ml und verdünnt mit 50ml Wasser (2)
- Davon nimmt man 50ml und verdünnt mit 50ml Wasser (3) Und so fort ……
Bei jeder Verdünnung misst man die Leitfähigkeit.
Trage in einer Grafik die Konzentration in g NaCl gegen die Leitfähigkeit auf.
Man kann dann aus der Kurve den Gesamtsalzgehalt als NaCl Konzentration bei einer beliebigen Leitfähigkeit ablesen.
Muster für die Anlage einer Eichkurve

Überlege:
Welche
Einschränkungen gelten bei diesem Verfahren?
Gewässer: Bakterien und Wasserpilze
Bakterien im Wasser Bakterien spielen bei der ökologischen Wasseruntersuchung eine herausragende Rolle. Sie stellen in Ökosystemen der Gewässer die häufigsten Destruenten. In Kläranlagen spielen sie – neben einigen Pilzen – die Hauptrolle bei der Wasseraufbereitung in Kläranlagen. Andererseits kann man mit der Bestimmung der Keimzahlen sehr genau den Gesundheitswert des Trinkwassers oder von Nahrungsmitteln für den Menschen feststellen. Ohne auf einzelne Bakterien und auf besonders wichtige Krankheitserreger einzugehen, soll hier nur das Prinzip experimentell aufgezeigt werden. Durch die Verwendung von Normalagar und Zimmertemperatur wird weitgehend verhindert, dass pathogene Keime wachsen. Trotzdem dürfen die Deckel nicht mehr abgehoben werden und die Platten müssen nach Gebrauch mit konzentrierter Prill Lösung oder 79%igem vergälltem Alkohol abgetötet werden. Die Kontrolle mit 1ml reinem Wasser wird parallel angesetzt, dazu noch eine unbehandelte Platte zum Nachweis, dass man die Platten steril hergestellt hat. Nach dem ersten Tag sollte man eine erste Kontrolle vornehmen! Test: Man bringt genau 1 ml der Wasserprobe (die wahrscheinlich verdünnt werden muss, empfehlenswert ist eine Startverdünnung 1 zu 1000) auf und verschließt sofort wieder. Durch vorsichtiges Schütteln verteilt man die Probe auf der gesamten Oberfläche des Nähragars.
Übersicht: https://www.google.com/search?client=firefox-b-d&q=bakterien Bakerienforschung https://www.innovations-report.de/html/berichte/medizin-gesundheit/neue-erkenntnisse-bakterienforschung-verbesserung-155929.html | ||
Versuch 8
Nachweis von Bakterien und Pilzen in Gewässern
Vorbereitung:
Käuflicher Standard - Nähragar wird nach Vorschrift in 200 ml Wasser gelöst und die Lösung ca. 20 min im Dampfkochtopf sterilisiert. Dann gibt man ca. 10 ml mit einer heißen, sterilen Pipette der noch heißen, flüssigen Lösung in sterile Petrischalen, lässt abkühlen und fest werden. Die Petrischalen kann man auf den Kopf gestellt im Kühlschrank einige Zeit aufbewahren.
1) Man löst Standard-Nähragar in Wasser auf, kocht auf und bringt alles in einem Erlenmeyer, den man mit einem Wattebausch verschließt und mit Alufolie abdeckt in den Dampfkochtopf (Vorsicht, das Glas nicht direkt auf den Metallboden stellen!) und autoklaviert 20 min lang. Alle noch anhaftenden Bakterien werden abgetötet.
2) Dann pipettiert man 10 ml des noch heißen und flüssigen fertigen Agar in sterile Petrischalen möglichst so, dass keine Bakterien oder Pilssporen übertragen werden. Bewährt hat sich für die Schule das vereinfachte Vorgehen mit einer leuchtenden Bunsenflamme.

Gesamtkeimzahl
aus einer strak verdünnten Wasserprobe
Bestimmung der Gesamtkeimzahl (Bakterien)
Die Kunst ist, eine geeignete Verdünnung zu wählen, bei zwar noch genügend Kolonien entstehen, die einzelnen Kolonien aber nicht auf dem Nährboden zu einer Masse zusammenwachsen, die man nicht mehr analysieren kann,
Diese Methode stellt das wissenschaftlich eingeführte Verfahren zur Feststellung der Gesamtzahl von Bakterien in einer Probe dar.
Außerdem kann man durch Wahl unterschiedlicher Nährböden die Bakterienarten weitgehend bestimmen. Hier wollen wir nur die Gesamtzahl der Bakterien feststellen, die auf Normalagar und bei Umgebungstemperatur wachsen (Standardnährböden).
Schon nach 24 Std. hat sich jedes Bakterium zu einer Kolonie vermehrt, die mit bloßem Auge sichtbar ist.
Versuch 9
Mikroskopischer Nachweis von Bakterien
Man kratzt mit einem Zahnstocher sehr vorsichtig einige Bakterien von einer Agarplatte ab, streicht sie in Wasser auf einem Objektträger aus und erhitzt sofort. Damit tötet man die Bakterien augenblicklich.
Mit dieser Methode lassen sich sehr rasch Bakterien in Zahnbelag, Abwasser, Kehricht, Staub u.a.m. nachweisen.
vgl. Gesundheit
Durchführung:
1) Man lässt einen Tropfen der Probe auf einem fettfreien, sauberen Objektträger eintrocknen.2) Dann zieht man den Objektträger durch die leuchtende Bunsenflamme oder Kerzenflamme. Die Bakterien werden abgetötet und fixiert.3) Dann bringt man einen Tropfen einer 2%igen Methylenblau- Lösung auf und spült nach 3 min ab.Die organischen Bestandteile der Probe haben sich nun blau gefärbt.4) Nach Trocknung beobachtet man mit bei stärkster Vergrößerung.Man erkennt die verschiedenen Bakterienformen, die eine begrenzte äußere Form – im Gegensatz zu sonstigem organischem Material – aufweisen.

Nachweis von Bakterien unter dem Mikroskop
Der Objektträger darf nicht an der Oberfläche berührt
und muss sofort nach Beobachtung in Prilwasser gesäubert werden!
Aufgabe: Foto mit dem Handy für das Protokoll
Versuch 11
Geruchs- und Trübungsmessungen
in Teichwasser, Flusswasser, Abwasser
Einen ersten Eindruck von Gewässerverschmutzung erhält man durch einen Trübungs- und Geruchstest
Material: verschiedene Wasserproben, als Kontrolle Leitungswasser
Geräte:
Bunsenbrenner, Glasgefäße, evt. Heizplatte
Aufgabe 1: Geruchsprobe
Man erwärmt das zu untersuchende Wasser leicht und riecht am Dampf


Aufgabe 2 Überprüfung der Farbe
Reines Wasser sollte klar, farblos und durchsichtig sein. Farbe deutet
immer auf Verschmutzung hin.

Aufgabe 3: Überprüfung der Sinkstoffe
Unter Sinkstoffen versteht man feine, feste Partikel, die sich nicht in
Wasser lösen.
Gerät: wissenschaftlicher Trichter mit Millimeter-Einteilung oder großer Trichter mit angeschlossener
10ml Pipette.
Zylinder für die Erfassung von Sinkstoffen


Gewässer: Giftstoffe
Schneider, V.
Für die Experimente mit Wasser aus Tümpeln, Bächen, Freibädern für den Unterricht braucht man gut verschließbare Plastikflaschen (250ml), einen Trichter und ein Auffanggefäß an einem Stock zur Probenentnahme.
Man kann auch Spülmittel oder Waschmittel als Gifte zur Untersuchung auswählen.
Gifte in Wasserproben und im Boden Gifte in Wasserproben oder Bodenproben lassen sich als Wachstumshemmung bei schnell wachsenden Lebewesen oder auch als Hemmung bestimmter, leicht beobachtbarer Stoffwechseläußerungen feststellen. z.B. lassen sich über die Sterberate von Insektenlarven noch feinste Spuren bestimmter Gifte im biologischen Test nachweisen, die chemisch überhaupt nicht zu erfassen wären. Für die Schule scheint der KRESSETEST besonders geeignet. Er bringt sehr gute Messergebnisse bei Schwermetallen, Säure- oder Basenbelastung und bei Detergentien (Spülmittel), wie auch Benzin und Erdöl. Die schulischen Vorteile dieses biologischen Tests mit Kresse sind:
Trotzdem sei der Hinweis erlaubt, dass der häufigste Fehler beim Versuch das Eintrocken lassen der Versuchspflanzen ist. Man kann in diesem Zusammenhang durchaus auch die experimentelle Verantwortlichkeit und das Durchhaltevermögen üben. Hier wird der Versuch auf die Giftigkeit von Spülmitteln beschränkt, weil die Schülerinnen und Schüler täglich damit umzugehen gelernt haben. Bemerkungen: Der Test gelingt auch mit Schwermetallsalzen wie Eisenchlorid. Der Test mit Chromsalzen ist wegen deren Giftigkeit nicht geeignet! Auch wirken Säuren oder Basen, doch lassen sich nur schwer die halbletalen Dosen ermitteln, da die Pflanzen zu empfindlich auf pH-Wert Änderungen reagieren. Messwert-Verfahren: Die „halbwirksame Dosis“ ist die Menge des Giftes, bei der 50% der Lebewesen Veränderungen gegenüber einer ausreichenden Zahl von Kontrollpflanzen zeigen. Von „halbletaler“ Dosis spricht man, wenn 50% der Lebewesen sterben.  Wie der Verlauf der theoretischen Kurve zeigt, ist die wirklich tödliche Dosis (100%) nicht quantitativ zu ermitteln, wohl aber sehr genau die halbletale Dosis oder die halbwirksame Dosis (50%). Studie „Pflanzenschutzmittel-Rückstände in Lebensmitteln. htttp://www.bfr.bund.de/cm/238/pflanzenschutzmittel _rueckstaende_in_lebensmitteln.pdf | ||
Versuch 10
Wirkung von Giften in Abwässern auf Lebewesen (Bio-test)
Aufgabe 1: Wirkung von Spülmittel
Material:
· Sehr saubere Petrischalen (nicht Pril gespült!) mit Filtrierpapier ausgelegt,
· handelsübliche Kressesamen, die man ca. 10 min vor Versuchsbeginn in sauberem Wasser quellen lässt.
· Spülmittel und Verdünnungen
Prinzipielle Durchführung:
Mit Hilfe einer Verdünnungsreihe nach dem angegebenen Schema erfasst man die Größenordnung der Giftwirkung: gewählte Messgrößen festlegen: z.B.% gekeimte Pflanzen, Wurzellängen nach 5 Tagen, Ausbildung der Kotyledonen nach 5 Tagen, …. uam.
Vorversuche: dieser Art stellt man fest, bei welchen Konzentrationen die beste Giftwirkung zu beobachten ist. Dann wählt man diesen Bereich aus und nimmt kleinere Verdünnungsschritte vor. Auf diese Weise lässt sich sehr genau die "tödliche Dosis" bestimmen.
Durchführung:
Man fertigt sich dann vorteilhaft eine Tabelle an, aus der der Versuchsaufbau und das Protokoll hervorgehen.
Hier ein Beispiel
Versuchsansatz:
Man gibt 5 ml Wasser und extra angesetzte Testlösung (mit der zu testenden Substanz) zusammen in eine Petrischale mit eingelegtem Küchenkrepp. Dann verteilt man mit der Pinzette etwa 20 Kressesamen in möglichst großem Abstand auf dem durchnässten Papier und deckt ab.
Meist kann man schon nach 2 Tagen die Auswertung vornehmen.
Die Messgrößen dabei sind: gekeimt ja oder nein / Länge des Würzelchens / Länge des Hypokotyls / Verlauf der Ergrünung
Aufgabe 1: Stellen Sie eine Grafik für die halbletale Dosis her! Bestimmen Sie die halbletale Dosis des verwendeten Spülmittels!
Aufgabe 2: Entwerfen Sie ein Versuchsdesign im biologischen Test zur Analyse der Giftwirkungen: z.B.:
2 g Streusalz bei Kresse,0,2 ml Benzin bei Kresse,0,1 ml Altöl bei Kresse,Blumendünger bei Kresse (nach Vorschrift)Salatöl bei KresseKeimhemmstoffe für Kartoffeln Wirkung auf KresseInsektensprays bei Kresse
Formulieren Sie die Versuchsergebnisse: Wo liegt die Halbletale Dosis?
Wie ist der biologisch-chemische Wirkungsweise?
Versuchsprotokoll Beispiel Kresse Test

Aufgabe 2: Stellen Sie in einer beschrifteten Grafik dar, wie hoch die halbwirksame Dosis von Pril gegenüber den Kontrollpflanzen
a) beim Keimungsverhalten bei Kresse
b) Beim Wurzelwachstum bei Kressepflänzchen c) Bei der Ausbildung der Keimblätter ist.
Man untersucht wenigstens 30 Pflänzchen im Hinblick auf die genannten Parameter und zählt aus.
Die „Halbwirksame Dosis“ ist die Menge des Giftes, bei der 50% der Lebewesen Veränderungen in den Bereichen a) bis c) gegenüber von 30 Kontrollpflanzen zeigen. Von „halbletaler“ Dosis spricht man, wenn 50% der Lebewesen sterben.
Aufgabe: Stellen Sie die Ergebnisse in einem Graphen dar, z. B.:
Einfluss der Giftmenge
auf das Überleben

Überlege: Aus dem Kurvenverlauf ist ersichtlich, warum man für die exakte Bestimmung von Gifteffekten die „Halbletale Dosis“ gewählt hat.
Wasserqualität „Güteklassen“
Weitere Informationen:
https://de.wikipedia.org/wiki/Wasserhaushalt
https://www.bmu.de/themen/wasser-abfall-boden/binnengewaesser/abwasser/
https://www.baulinks.de/webplugin/2015/0521.php4
https://de.dwa.de/de/?utm_source=baulinks&utm_campaign=baulinks
https://www.bmu.de/themen/wasser-abfall-boden/binnengewaesser/fluesse-und-seen/zustand-der-oberflaechengewaesser/
Info: Der Sauerstoffgehalt ist ein sehr wichtiger physikalischer Indikator für die Beurteilung eines Sees, Tümpels, eines Fließgewässers, Meeres, oder der Tiefsee…). Weil sich Sauerstoff nur sehr langsam in Wasser löst und kaltes Wasser mehr Sauerstoff aufnehmen kann als warmes Wasser, gilt allgemein:
Je höher die Temperatur des Wassers, umso niedriger der Sauerstoffgehalt und Je höher die Durchmischung (z.B. durch Wind), umso höher der bei dieser Temperatur mögliche Sauerstoffgehalt. Sauerstoffsättigung (höchst möglicher Sauerstoffgehalt) bei einer bestimmten Temperatur:

Auf Grund der Sauerstoffzehrung durch tierische Lebewesen ist der wirkliche Gehalt an Sauerstoff in natürlichen Gewässern meist sehr viel niedriger! Ein Sauerstoffgehalt unter 5 ppm ist z. B. auch für den recht unempfindlichen Karpfen tödlich. Daher wird verständlich, dass das „Fischsterben“ besonders in Sommermonaten einsetzt in Flüssen, deren Wasser als Kühlwasser genutzt wird und daher deutlich wärmer ist als das Wasser vor der Nutzung.
Meßprinzip: Mangansulfat bildet in wässriger Lösung unter Zusatz von NaOH weißes Manganhydroxid. Dieses Hydroxid hat die Eigenschaft, Sauerstoff anzulagern und sich dabei braun zu färben.
Mn SO4 + 2 NaOH ------> Mn (OH)2 + Na2SO4 Weißer Niederschlag
Mn (OH)2 + 1/2 O2 ------> Mn0(OH)2 Brauner Niederschlag
Diese Reaktion macht man sich zu Nutze, um den ungefähren Sauerstoffgehalt mit Hilfe der Farbe in einem Probenwasser zu bestimmen.
Versuch 1
Gehalt an Sauerstoff in einer Gewässerprobe
(stark vereinfacht nach Winkler)
Die beiden benötigten Pipetten dürfen nicht vertauscht werden! Sorgfältig arbeiten! Giftige Substanzen beachten!
1) Man lässt aus der luftblasenfrei verschlossenen Probenflasche mehrere Volumina des Probenwassers durch die Messflasche laufen, damit wirklich auch der Sauerstoffgehalt der Probe gemessen werden kann.2) Das Testgefäß muss vollständig mit Testwasser gefüllt sein.3) Zugabe mit Pipette (1) von 1 ml einer 30 %igen Mangansulfatlösung;4) Zugabe mit Pipette (2) von 1 ml einer 32 %igen Natronlaugelösung (Vorsicht!!);
5) Aufsetzen eines Stopfens, luftblasenfrei;
Versuchsablauf der Sauerstoffmessung

Nach rund 10 min erhält man eine Färbung, die den Sauerstoff im Testgefäß anzeigt:
Eichung: Farbe Gehalt in ppm
weiß 0,0
elfenbein 2 - 5
schwach braun 5 - 10
kaffeebraun 10 - 15
Messergebnisse:
Probe1______________________ ppm _______
Probe2______________________ ppm _______
usf.
Versuch 2
Sauerstoffzehrung in einer Gewässerprobe
Unter Sauerstoffzehrung versteht man die Abnahme des Sauerstoffgehalts von Wasserproben in der Zeit. Die Abnahme geht auf die Atmungstätigkeit von Bakterien, Pilzen und Kleintieren zurück. Sie ist ein gutes Maß für den Nährstoffgehalt von Gewässern und die Aktivität von Destruenten. Je stärker die Sauerstoffzehrung, umso verschmutzter ist das Gewässer. Aber: es gibt Abwässer, die so giftig sind, dass auch keine Sauerstoffzehrung stattfindet.
Messung: Bei der normalen Atmung wird Sauerstoff verbraucht und Kohlenstoffdioxid ausgeschieden. Wenn man in einem geschlossenen Raum das Kohlenstoffdioxid an NaOH bindet, bleibt der Sauerstoff übrig. Man kann dann mit Hilfe eines Manometers direkt die Abnahme der Sauerstoffmenge in der überstehenden Luft messen. Meist misst man 5 Tage lang, die Sauerstoffzehrung wird unter dem Kürzel BSB5 angegeben (biologischer Sauerstoffverbrauch).
Messung des Sauerstoffverbrauchs in Gewässerproben
Beim Versuch ist zu beachten, dass man das NaOH wegen seiner Giftigkeit nicht mit dem Probenwasser in Verbindung bringen darf.

Aufgabe 1: Stellen Sie sich wenigstens zwei Messapparaturen nach der Abbildung zusammen.
Achten Sie auf absolute Luftdichtigkeit. Diese muss 5 Tage lang gewährleistet sein.
Versuch:
1. Man füllt 500ml Probenwasser in das Messgefäß.2. noch offen gut umrühren, damit sich die Probe mit Sauerstoff sättigt.3. Dann bringt man mit einer Pinzette vorsichtig 1 Plätzchen NaOH in ein 10ml Glas mit Schnappdeckel,
das man zuvor mit einer Drahtvorrichtung zum Einhängen in das Messgefäß versehen hat.4. Nun alles luftdicht verschließen und bei Zimmertemperatur im Schatten laufen lassen. Evtl. mit Dauerplastik abdichten5. Nach einem Tag am Manometer nachsehen, ob sich das Volumen verändert hat.6. Nach 5 Tagen Laufzeit den Verbrauch von Sauerstoff notieren.
Kontrolle: Im zweiten Gerät setzt man einen Versuch mit reinem Leitungswasser an!
Tipp: Das Versuchswasser sollte ständig umgerührt werden, da sich Sauerstoff nur sehr schwer in Wasser löst. Die Messwerte sind temperaturabhängig. Daher bei derselben Temperatur ablesen.
Fragen: Warum ist es sinnvoll, das Messgefäß abzudunkeln? Welche Werte werden in Abwässern erreicht? Gibt es auch einen nicht-biologisch zu begründeten Sauerstoffverbrauch in Abwässern?
Messergebnis:
Probe1______________________ ppm _______
Ist ein Fischsterben auf Grund der Messergebnisse wahrscheinlich?
Versuch 3
Bestimmung der Wassergüte mit Leitorganismen
Als Leitorganismen hat man die Lebewesen festgelegt, die besonders häufig in einer Gewässerprobe anzutreffen sind.
Aufgabe: Stelle von einer Wasserprobe fest, welche Leitorganismen vorhanden sind und welcher Güteklasse sich daraus ergibt.
Nach der Beobachtung mit dem Mikroskop gib die Tiere wieder in die Probe zurück und gieße das Wasser am Entnahmeort wieder aus.
Wasserprobe Nr. …………………. Gefundene Wassergüteklasse: ……………
Güteklasse 1
wenige Nährstoffe, hoher Sauerstoffgehalt, geringe Sauerstoffzehrung

Güteklasse 2
Nährstoffe vorhanden, wechselnder Sauerstoffgehalt, etwas Sauerstoffzehrung

Güteklasse 2-3
viele Nährstoffe, mittlerer Sauerstoffgehalt, große Sauerstoffzehrung

Güteklasse 3
Viele Nährstoffe, geringer Sauerstoffgehalt, große Sauerstoffzehrung

Güteklasse 4
viele Nährstoffe, kaum Sauerstoff, sehr hohe Sauerstoffzehrung

Übersicht über die Qualitätsstufen der Gewässser


